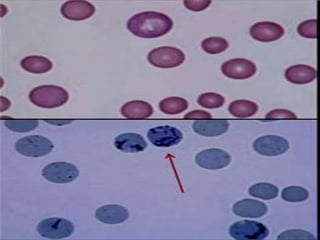

The document provides a comprehensive overview of erythrocytes, including their dimensions, functions, and the process of erythropoiesis, which involves the formation and maturation of red blood cells. It details the normal count of red blood cells, variations in size and shape, the stages of erythropoiesis, and the factors necessary for their development, including hormones and vitamins. Additionally, it explains the roles of erythropoietin, vitamin B12, and folic acid in red blood cell production and functionality.